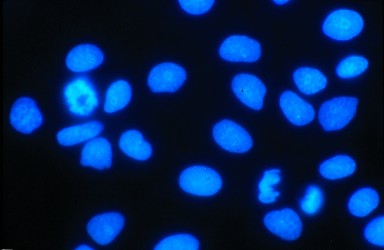

|
|
| Author |
Message |
willmer
Joined: 23 Mar 2012
Posts: 2
|
Posted: Fri Mar 23, 2012 10:16 am Post subject: photoshop for science...need some help |
|
|
Hello, I am a biology researcher who has very minimal photoshop experience. I often take pictures of cells and focus on their nuclei, the part of the cell that holds DNA. When I take pictures with our microscope, often there is a lot of background color that makes it difficult to distinguish the nuclei. Unfortunately, our microscope does not quite work for the kind of imaging I'm doing but I would like to see if its possible to salvage the images I have already taken. When I try to edit the levels in PS, I can manage a slightly better picture, but is there a way to take the pictures I have included that are black and white and make them as clear as the picture I attached with the blue nuclei?
| Description: |
| This is my original image from the microscope. Instead of clear differences between a black background and blue/white nuclei, it is all different shades of grey. |
|
| Filesize: |
95.74 KB |
| Viewed: |
427 Time(s) |

|
| Description: |
| This is what I want my images to look like. Clear distinction between the nuclei (blue) and a black background. The nuclei here have been pseudo colored blue. |
|
| Filesize: |
15.72 KB |
| Viewed: |
427 Time(s) |
|
|
|
|
|
|
 |
thehermit
Joined: 05 Mar 2003
Posts: 3987
Location: Cheltenham, UK
|
|
|
|
|
 |
willmer
Joined: 23 Mar 2012
Posts: 2
|
Posted: Fri Mar 23, 2012 11:41 am Post subject: |
|
|
Thanks for the attempt. Its not the blue color that interests me as much, but rather the distinction between the nuclei and the background. I would love to see the PSD tho and figure out what changes you made. My emails is soccerislife61488 "at" yahoo.com
|
|
|
|
|
 |
|